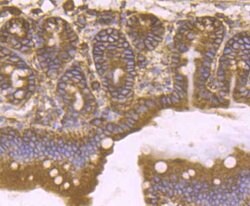
Invitrogen KDEL Recombinant Rabbit Monoclonal Antibody (JB42-04) 100 &mu;L | Buy Online | Invitrogen&trade; | Fisher Scientific

missing translation for 'onlineSavingsMsg'
Learn More
Learn More
Invitrogen™ KDEL Recombinant Rabbit Monoclonal Antibody (JB42-04)


Description
Positive Control: Rat testis tissue, Mouse testis tissue, 293, HepG2, A549, 293T, rat epididymis tissue, human placenta tissue, human stomach cancer tissue, mouse small intestine tissue.
The sequence Lys-Asp-Glu-Leu (KDEL) or a closely related sequence, is present at the carboxy-terminus of soluble endoplasmic reticulum (ER) resident proteins and some membrane proteins. 78 and 94 kDa glucose regulated proteins, GRP78 and GRP94 respectively, and protein disulfide isomerase (PDI) all share the C-terminal KDEL sequence. The presence of carboxy-terminal KDEL appears to be necessary for ER retention and appears to be sufficient to reduce the secretion of proteins from the ER. This retention is reported to be mediated by a KDEL receptor.

Specifications
Specifications
| Antigen | KDEL |
| Applications | Flow Cytometry, Immunohistochemistry (Paraffin), Western Blot, Immunocytochemistry |
| Classification | Recombinant Monoclonal |
| Clone | JB42-04 |
| Concentration | 1 mg/mL |
| Conjugate | Unconjugated |
| Formulation | TBS with 0.05% BSA, 40% glycerol and 0.05% sodium azide; pH 7.4 |
| Gene | HSPA5 |
| Gene Accession No. | P06761, P08113, P11021, P14625, P20029, P24390, Q569A6, Q66HD0, Q99JH8 |
| Gene Alias | 78 kDa glucose-regulated protein; 8030486F04Rik; 94 kDa glucose-regulated protein; 94 kDa glucose-regulated protein {ECO:0000250; AL022860; AU019543; AW215843; baffled; Binding-immunoglobulin protein; BiP; D2Wsu141e; D2Wsu17e; ECGP; Endoplasmic reticulum chaperone BiP; endoplasmic reticulum lumenal Ca(2+)-binding protein grp78; endoplasmic reticulum resident protein 58; Endoplasmic reticulum resident protein 99; Endoplasmin; endoplasmin {ECO:0000250; endothelial cell (HBMEC) glycoprotein; EP58; epididymis luminal protein 35; epididymis secretory sperm binding protein Li 125m; epididymis secretory sperm binding protein Li 89n; ER lumen protein retaining receptor 1; ER lumen protein-retaining receptor 1; ER protein 58; ERD2; Erd2.1; ERp58; ERp99; glucose regulated protein, 78 kDa; glucose-regulated protein; glucose-regulated protein, 78kDa; gp96; gp96 homolog; GRP 78; Grp78; GRP-78; GRP94; GRP-94; HDEL; heat shock 70 kDa protein 5; heat shock 70kD protein 5; heat shock 70kD protein 5 (glucose-regulated protein, 78kD); heat shock 70kDa protein 5 (glucose-regulated protein); heat shock 70kDa protein 5 (glucose-regulated protein, 78kDa); heat shock protein 5; Heat shock protein 70 family protein 5; heat shock protein 90 beta family member 1; heat shock protein 90 kDa beta member 1; heat shock protein 90 kDa beta member 1 {ECO:0000250; heat shock protein 90, beta (Grp94), member 1; heat shock protein 90, beta, member 1; heat shock protein 90kDa beta (Grp94), member 1; heat shock protein 90kDa beta family member 1; heat shock protein family A (Hsp70) member 5; Heat shock protein family A member 5; HEL35; HEL-S-125m; HEL-S-89n; Hsce70; HSP70 family protein 5; Hsp90b1; hsp90b1 {ECO:0000250; HSPA5; I79_019946; I79_020931; Immunoglobulin heavy chain-binding protein; KDEL; KDEL (Lys-Asp-Glu-Leu) containing 1; KDEL (Lys-Asp-Glu-Leu) endoplasmic reticulum protein retention receptor 1; KDEL endoplasmic reticulum protein retention receptor 1; KDEL motif containing 1; KDEL motif-containing 1; KDEL motif-containing protein 1; KDEL receptor 1; KDEL1; KDELC1; KDELR1; Lys-Asp-Glu-Leu; mBiP; MIF2; PM23; POGLUT2; Polymorphic tumor rejection antigen 1; Protein O-glucosyltransferase 2; Protein O-xylosyltransferase POGLUT2; Putative MAPK-activating protein PM23; RP23-446N16.1; Sez7; SEZ-7; Steroidogenesis-activator polypeptide; stress-inducible tumor rejection antigen gp96; TA-3; Targ2; Tra1; Tra-1; transforming growth factor alpha regulated gene 2; tumor rejection antigen (gp96) 1; tumor rejection antigen 1; Tumor rejection antigen gp96; UniProtKB:P08113}; UNQ1910/PRO4357; XAP-1 antigen |
| Show More |
Product Title
By clicking Submit, you acknowledge that you may be contacted by Fisher Scientific in regards to the feedback you have provided in this form. We will not share your information for any other purposes. All contact information provided shall also be maintained in accordance with our Privacy Policy.
Spot an opportunity for improvement?